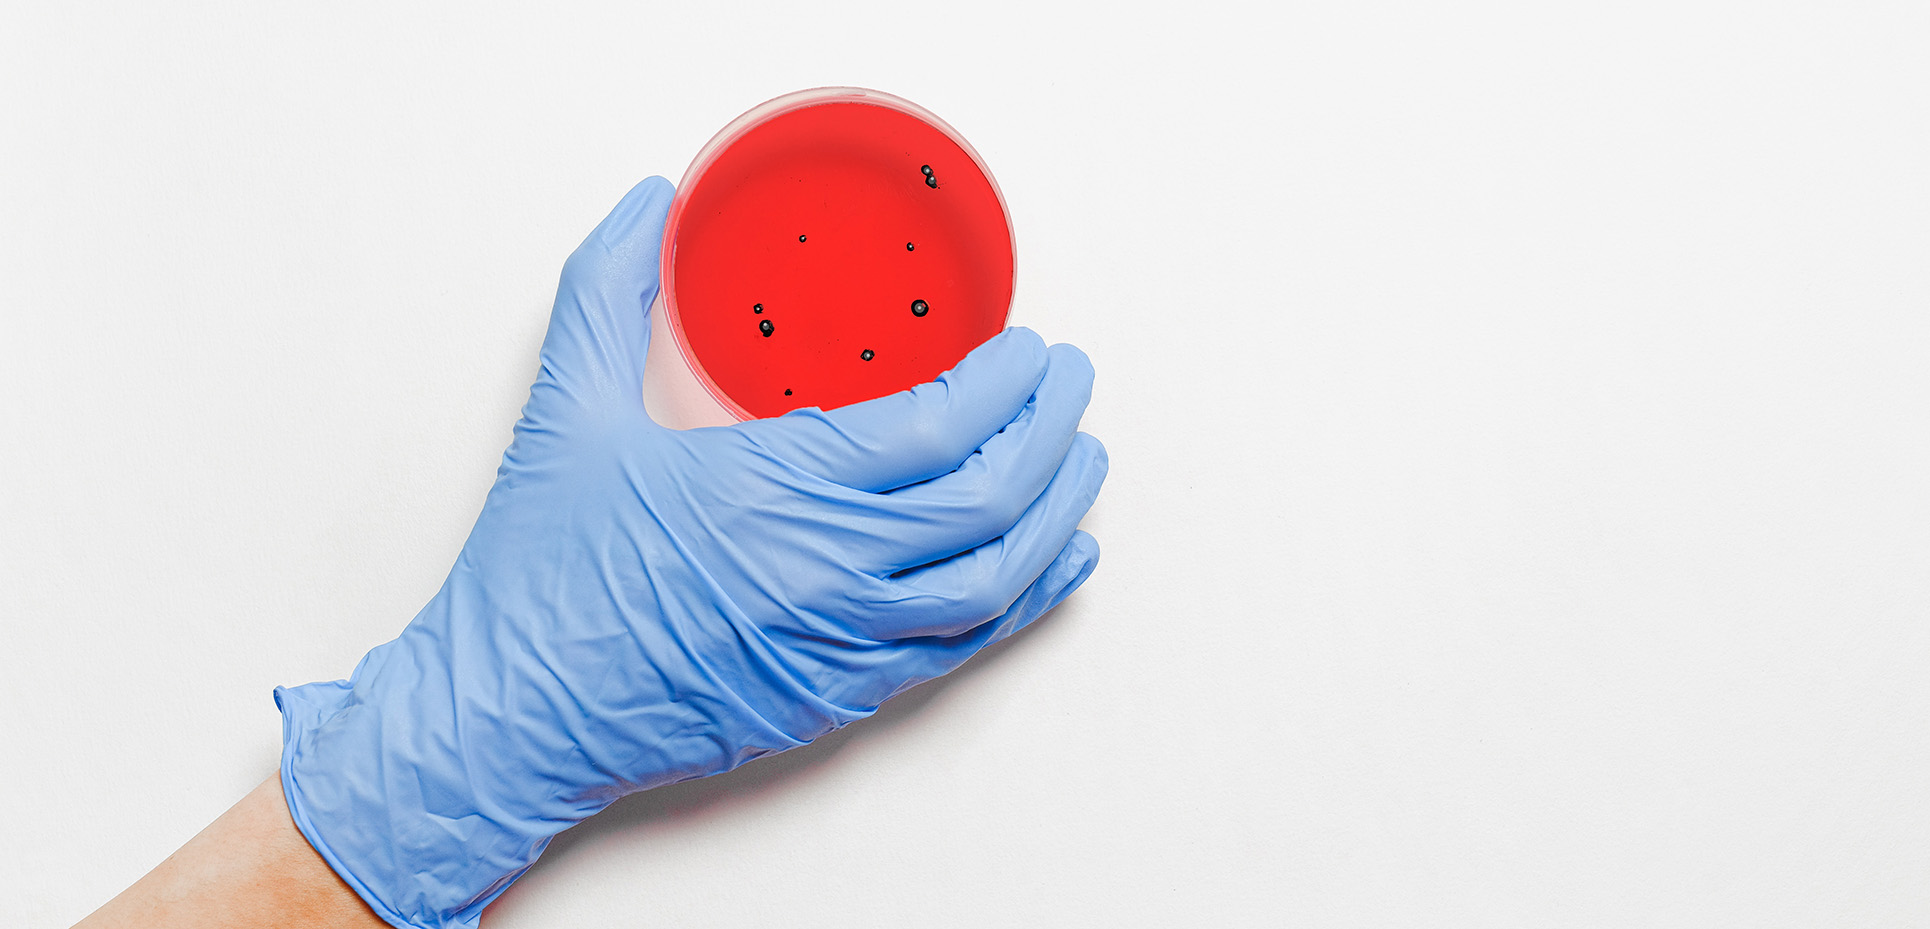
Medizin Karriere in der Forschung

5 Top-Arbeitgeber für deine Medizinkarriere

Erinnerst du dich? Wir haben dir schon einmal Arbeitgeber präsentiert, die ideal zu deinem Studiengang passen und dir eine Karriere auch abseits des Krankenhauses verschaffen. Hier kommt ein weiterer Aufschlag mit fünf neuen Arbeitgebern für deine Medi-Karriere!
Deine Perfect Matches
1. Karriere mit Sinn
Dir war es schon immer wichtig, dass dein zukünftiger Job eine gewisse Sinnhaftigkeit verfolgt, richtig? Die medizinische Nothilfe von Ärzte ohne Grenzen ist unserer Meinung nach genau das Richtge für dich: Du kannst jetzt schon neben der Uni deinen Betrag für eine bessere Welt leisten.

Mehr erfahren & etwas bewegen!
2. Etwas ganz anderes: Mit Data Science Medizin revolutionieren
Wie wäre es, an Projekten zu arbeiten, welche Medikamente und Behandlungsmöglichkeiten der Zukunft maßgeblich mitbestimmen? Verena von Boehringer Ingelheim weiß es und erzählt es dir in dieser Podcastfolge in knackigen 16 Minuten:
3. Was kommt nach Corona?
...wissen wir nicht. Was wir wissen ist, dass der Pharmakonzern Pfizer nach wie vor ein Arbeitgeber mit Sicherheit ist! Hier arbeitest du an zukunftsträchtigen Themen, welche aktuelle Herausforderung behandeln.
Zum Unternehmensprofil von Pfizer
4. Den Fragen der Zeit nachgehen
Im Job theoretische Modelle simulieren, die Phänomene der Natur beschreiben sollen: So sieht Maditas Arbeitsalltag am Forschungszentrum Jülich aus.
Mehr über das Forschungszentrum Jülich erfahren
5. Was machen Life-Science-Unternehmen?
Fortschritte bei der Suche nach einer Heilung für Diabetes machen. Einen neuen Behandlungsansatz gegen Adipositas entwickeln. Das Leben mit Hämophilie (genetisch bedingte Blutgerinnungsstörung) weiter verbessern. Diese und weitere Projekte kannst du bei Novo Nordisk anpacken.
